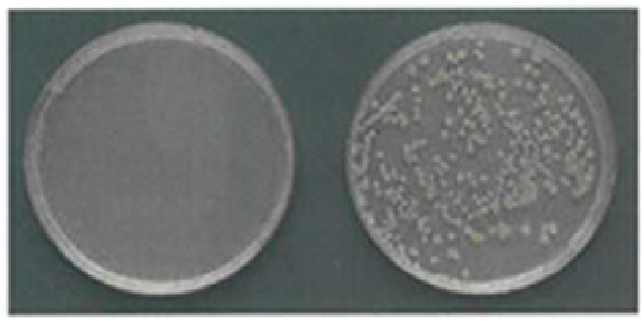
抗菌性能

公司简介
吉林省埃米涂层科技有限公司隶属于南京富莱德控股有限公司,南京富莱德控股有限公司成立于2025年10月,下设“吉林省埃米涂层科技有限公司”和“广州富莱德新材料有限公司”,是一家专注于研发,生产和销售埃米玻璃涂层的科技型企业。公司科研团队于2010年实现了埃米玻璃涂层技术的产业化,推出了建筑外表面永久洁净、玻璃外表面斥水永久洁净、金属外表面防锈、汽车外表面洁净、卫浴表面无水渍并持久性杀菌等一系列解决方案。

吉林省埃米涂层科技有限公司隶属于南京富莱德控股有限公司,南京富莱德控股有限公司成立于2025年10月,下设“吉林省埃米涂层科技有限公司”和“广州富莱德新材料有限公司”,是一家专注于研发,生产和销售埃米玻璃涂层的科技型企业。公司科研团队于2010年实现了埃米玻璃涂层技术的产业化,推出了建筑外表面永久洁净、玻璃外表面斥水永久洁净、金属外表面防锈、汽车外表面洁净、卫浴表面无水渍并持久性杀菌等一系列解决方案。

埃米级水质玻璃可在涂层表面形成密不透风的5μm厚度的玻璃。将锈因子及水分子完全隔离开,并抗紫外线光照和强酸,起到防锈功能。
表面形成的玻璃硬度等级可达到9H并耐摩擦。
水分子及油脂无法在玻璃表面停留,灰尘会被分解并被流水带走,物体表面始终保持清洁。
全球首例实现光触媒和埃米级水质玻璃相融合的技术突破,可达到持久杀菌、自清洁、去味的效果。
玻璃表面最高可承受1600°高温
埃米涂层技术已成功应用于多个领域,从工业设备到建筑外墙,从海洋工程到公共设施,我们的产品为客户提供了全方位的防护解决方案。以下是我们精选的部分成功案例,展示了埃米涂层在不同场景下的卓越表现。













埃米级水质玻璃涂层可应用在建筑物的外表面,通过杰出的自清洁功能,使建筑外表面或玻璃幕墙保持长时间的洁净状态,大幅降低维护成本。



埃米级水质玻璃涂层具备超强杀菌、去味和抗摩擦功能。可使影院,剧院,公共洗手间,地铁、公共交通受保护部分长期保持无菌状态并具备抗磨擦性能,大幅降低消杀维护成本,延长设施的使用寿命。



埃米级水质玻璃涂层可附着在室内贵重家的表面,防止家具被硬物损坏,易清洁。玻璃涂层可有效保护室内墙壁,防止老化变黄。



埃米级水质玻璃涂层具备优秀的斥水及抗酸性。可在火车、船舶、汽车的外表面形成保护层,只需清水或自然雨水即可把附着物轻松洗掉。同时可以阻止海水对于轮船漆面的侵蚀,减少海洋生物在船体的附着并极易清除。

埃米玻璃颗粒扩散吸附在漆面表层形成高持久性玻璃保护层
埃米玻璃被上层与底层隔离形成高光泽度玻璃保护层
埃米玻璃与空气进行化学反应形成高抗污性玻璃保护层

使用已知硬度的铅笔,在一定的条件下,对埃米级隐形玻璃涂层进行刮划测试,以检测埃米级隐形玻璃涂层表面抗划刮能力。

5000 小时抗紫外线测试保护漆面可达16年。高厚度、高透亮性水质玻璃为基材带来熠熠光彩。本品还兼具抗紫外线功能及高抗污功能,对基材漆面的持续保护可达16年之久。

水渍,雨水无法在表面停留,灰尘也会被分解并被水流自动冲走、不留痕迹
各种油脂无法在玻璃表面附着,易清洁
硫酸、盐碱无法破坏玻璃表面。将玻璃附着在铜板表面进行强酸喷雾实验,通过电子显微镜显示,无腐蚀现象
水质玻璃表面无法培殖细菌,图左是在在最少荣养培养皿中涂抹,撒上 E.coli1*10^6个/100μ1 之后的结果,图右则是同培养皿中撒入同量 E.coli 的结果。
与国内外487家知名企业保持良好合作








